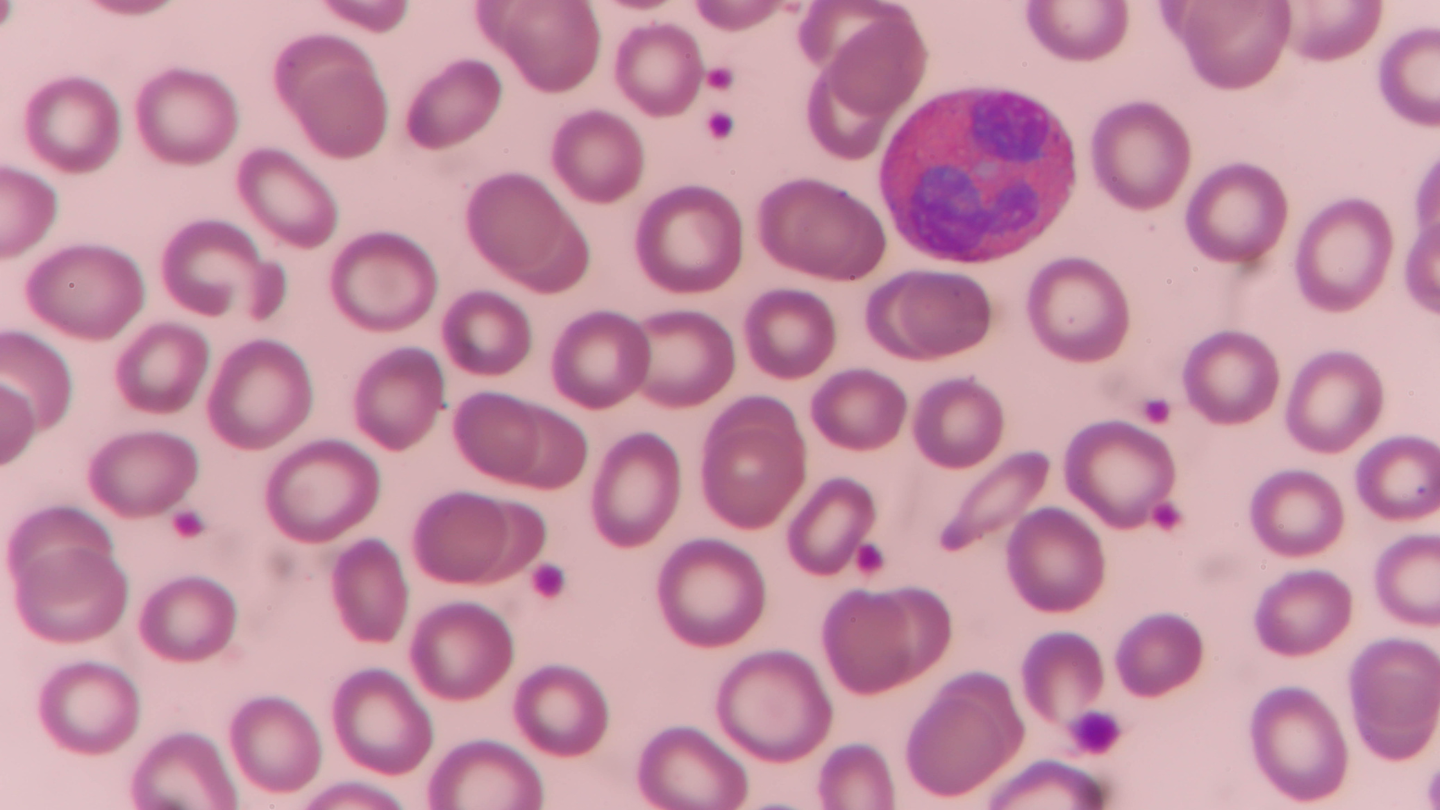
Tỷ lệ bạch cầu lympho tăng là gì?

Bạch cầu lympho là một loại tế bào bạch cầu đóng vai trò quan trọng trong hệ miễn dịch, giúp cơ thể nhận diện và tiêu diệt các tác nhân gây bệnh như virus, vi khuẩn hoặc tế bào bất thường. Khi xét nghiệm công thức máu cho thấy bạch cầu lympho tăng, nhiều người lo lắng không biết điều này có nguy hiểm hay không. Hiểu rõ ý nghĩa của chỉ số này sẽ giúp bạn nhận biết khi nào là phản ứng bình thường của cơ thể và khi nào cần đi khám để kiểm tra thêm. Bài viết dưới đây sẽ cung cấp thông tin chi tiết về bạch cầu lympho tăng, từ nguyên nhân phổ biến đến dấu hiệu cần lưu ý, giúp bạn chủ động bảo vệ sức khỏe.
Tỷ lệ bạch cầu lympho tăng là gì? Chỉ số bao nhiêu được coi là cao
Tỷ lệ bạch cầu lympho trong máu tăng (lymphocytosis) là tình trạng số lượng hoặc tỷ lệ phần trăm bạch cầu lympho trong máu cao hơn mức bình thường. Đây là một trong những bất thường thường gặp khi làm xét nghiệm máu tổng quát (CBC - Complete Blood Count).
Mức lympho được đánh giá theo hai cách chính:
- Dựa trên số lượng tuyệt đối: Ở người trưởng thành khỏe mạnh, số lượng lympho bình thường khoảng 1.000 - 4.000 tế bào/µL máu; khi trên 4.000 tế bào/µL được xem là tăng lympho, còn ở trẻ em mức bình thường có thể cao hơn, khoảng 5.000 - 7.000 tế bào/µL.
- Dựa trên tỷ lệ phần trăm trong công thức máu: Tỷ lệ lympho bình thường khoảng 20 - 40% tổng số bạch cầu; khi trên 40% có thể được xem là tăng lympho tương đối, tuy nhiên bác sĩ thường đánh giá đồng thời cả số lượng tuyệt đối và tỷ lệ phần trăm để có kết luận chính xác.
Tuy nhiên, bác sĩ thường đánh giá đồng thời cả số lượng tuyệt đối và tỷ lệ phần trăm, vì tỷ lệ có thể tăng khi các loại bạch cầu khác (như bạch cầu trung tính) giảm tạm thời. ạch cầu lympho tăng không phải lúc nào cũng phản ánh bệnh lý nghiêm trọng.
Nguyên nhân khiến tỷ lệ bạch cầu lympho trong máu tăng
Có nhiều nguyên nhân khác nhau dẫn đến tỷ lệ bạch cầu lympho trong máu tăng, từ các bệnh nhiễm trùng thông thường đến một số bệnh lý nghiêm trọng hơn.
Nhiễm virus
Nguyên nhân phổ biến nhất của tình trạng tăng lympho là các bệnh nhiễm virus, chẳng hạn như:
- Cúm;
- Sởi;
- Thủy đậu.
- Rubella;
- Viêm gan virus;
- Nhiễm virus Epstein–Barr (gây bệnh tăng bạch cầu đơn nhân - mononucleosis);
- HIV.
Trong những trường hợp này, hệ miễn dịch sản xuất nhiều lympho hơn để tiêu diệt virus, dẫn đến tỷ lệ bạch cầu lympho trong máu tăng tạm thời.

Nhiễm khuẩn hoặc ký sinh trùng
Một số bệnh nhiễm khuẩn cũng có thể gây tăng lympho, chẳng hạn:
- Ho gà;
- Lao;
- Một số nhiễm trùng mạn tính.
Tuy nhiên, nhiễm vi khuẩn thường làm tăng bạch cầu trung tính nhiều hơn lympho.
Bệnh lý về máu và hệ bạch huyết
Trong một số trường hợp hiếm hơn, tỷ lệ bạch cầu lympho trong máu tăng có thể liên quan đến bệnh lý huyết học, ví dụ:
- Bệnh bạch cầu lympho mạn tính (CLL);
- U lympho (lymphoma);
- Một số rối loạn tăng sinh lympho.
Những bệnh này thường khiến lympho tăng kéo dài, kèm theo các dấu hiệu bất thường khác như hạch to, mệt mỏi kéo dài.
Các nguyên nhân khác
Ngoài nhiễm trùng và bệnh máu, một số yếu tố khác cũng có thể làm tăng lympho:
- Hút thuốc lá;
- Căng thẳng cấp tính;
- Phẫu thuật cắt bỏ lá lách;
- Bệnh tự miễn (như lupus);
- Phản ứng với thuốc hoặc vắc xin.

Tỷ lệ bạch cầu lympho trong máu tăng có gây triệu chứng không?
Trong nhiều trường hợp, bạch cầu lympho tăng không gây triệu chứng rõ ràng. Tình trạng này thường được phát hiện tình cờ khi làm xét nghiệm máu định kỳ hoặc khám sức khỏe. Tuy nhiên, nếu nguyên nhân là bệnh lý tiềm ẩn, người bệnh có thể gặp các dấu hiệu như:
- Sốt;
- Mệt mỏi;
- Đổ mồ hôi ban đêm;
- Hạch bạch huyết sưng;
- Sụt cân không rõ nguyên nhân;
- Nhiễm trùng kéo dài.
Một số bệnh nhiễm virus như tăng bạch cầu đơn nhân còn có thể gây đau họng, lách to, nổi hạch cổ. Các triệu chứng này không phải do lympho tăng trực tiếp, mà do bệnh lý gây ra sự tăng lympho.

Khi nào bạch cầu lympho tăng cần đi khám?
Không phải mọi trường hợp bạch cầu lympho tăng đều nguy hiểm. Tuy nhiên, bạn nên đến cơ sở y tế nếu gặp một trong các tình huống sau:
- Tỷ lệ lympho tăng kéo dài hơn vài tuần hoặc vài tháng;
- Số lượng lympho tăng rất cao trong xét nghiệm máu;
- Có các triệu chứng như sốt kéo dài, mệt mỏi không rõ nguyên nhân, sụt cân, nổi hạch, nhiễm trùng tái phát.
Bác sĩ có thể chỉ định một số xét nghiệm để xác định nguyên nhân, chẳng hạn:
- Công thức máu toàn phần (CBC);
- Xét nghiệm phân loại bạch cầu;
- Xét nghiệm miễn dịch (như xét nghiệm virus EBV, CMV);
- Xét nghiệm tủy xương trong trường hợp nghi ngờ bệnh lý huyết học.

Cách kiểm soát và theo dõi khi bạch cầu lympho tăng
Việc điều trị không tập trung vào việc giảm lympho mà nhắm vào nguyên nhân gây ra tình trạng này.
Điều trị nhiễm trùng
Nếu bạch cầu lympho tăng do nhiễm trùng:
- Nhiễm virus: Điều trị triệu chứng, nghỉ ngơi, bổ sung nước và dinh dưỡng;
- Nhiễm vi khuẩn: Có thể cần kháng sinh theo chỉ định bác sĩ.
Sau khi bệnh được kiểm soát, số lượng lympho thường trở về bình thường.
Điều trị bệnh lý nền
Nếu nguyên nhân là bệnh lý về máu hoặc hệ miễn dịch, bác sĩ có thể áp dụng các phương pháp như thuốc điều hòa miễn dịch, hóa trị, xạ trị hoặc ghép tế bào gốc trong trường hợp đặc biệt.
Theo dõi sức khỏe định kỳ
Để phát hiện sớm các bất thường về máu, bạn nên:
- Khám sức khỏe định kỳ;
- Xét nghiệm máu khi có triệu chứng bất thường;
- Duy trì lối sống lành mạnh như ăn uống đầy đủ dinh dưỡng, ngủ đủ giấc, tập thể dục thường xuyên, hạn chế hút thuốc và rượu bia.
Tỷ lệ bạch cầu lympho tăng thường là dấu hiệu cho thấy hệ miễn dịch đang hoạt động để bảo vệ cơ thể trước nhiễm trùng hoặc các tác nhân gây bệnh. Trong nhiều trường hợp, đây là phản ứng sinh lý bình thường và sẽ trở về mức bình thường khi bệnh lý nền được kiểm soát. Tuy nhiên, nếu chỉ số lympho tăng kéo dài hoặc đi kèm các triệu chứng như sốt, nổi hạch, sụt cân hay mệt mỏi kéo dài, bạn nên đi khám để được đánh giá kỹ hơn. Việc phát hiện sớm nguyên nhân sẽ giúp điều trị kịp thời và bảo vệ sức khỏe lâu dài. Hy vọng bài viết này đã giúp bạn hiểu rõ hơn về bạch cầu lympho tăng, từ đó chủ động chăm sóc sức khỏe cho chính mình và gia đình. Chúc bạn luôn khỏe mạnh!
:format(webp)/470051785_8767135473405056_691967411107495592_n_6b2bbff755.png)
:format(webp)/467434554_545745841560409_1066418224364723785_n_560a494f9c.png)
/xet_nghiem_tck_la_gi_vai_tro_trong_roi_loan_dong_mau_558bed99c2.jpg)
/6_7239b13ad1.png)
/6_1519506378.png)
/chi_so_triglyceride_cao_co_nguy_hiem_khong_cach_kiem_soat_va_phong_ngua_triglyceride_cao_1_82e6481c21.jpg)
/homocysteine_la_gi_y_nghia_chi_so_homocysteine_ma_ban_can_biet_f8d000ae65.jpg)